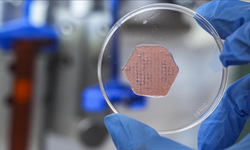
İYTE’de geliştirilen probiyotik yara örtüsü kronik yaraların iyileşmesine umut oluyor

Proje, Suriyeli sığınmacı ve yerli kadınların toplumsal uyumunu artırmayı hedefliyor. Kadınlar, servisle evlerinden alınıp çocuklarıyla birlikte atölyeye getirildi. Eğitim sırasında hem keyifli vakit geçiren katılımcılar hem de üretim deneyimi yaşadı. DEÜ Edebiyat Fakültesi Psikoloji Bölümü Öğretim Üyesi Prof. Dr. Serap Akfırat, projenin amaçlarını şöyle anlattı: “Ön yargıları kırmak ve kaynaşmayı sağlamak için iki grubu seramik atölyesinde bir araya getirdik. Katılımcıları farklı gruplara ayırarak seramikle birlikte psikososyal destek alanların iyi oluşlarının artacağını, ön yargıların azalacağını öngördük. Ayrıca sosyoekonomik olarak dezavantajlı kadınlara üretim deneyimi yaşatmayı hedefledik.”
''Kadın olmak ortak kimlik''
Prof. Dr. Akfırat, hazırlanan seramik eserlerin 29 Mart’ta DEÜ Sürekli Eğitim Merkezi’nde (DESEM) sergileneceğini belirtti. Katılımcılar yoga, nefes ve basit rahatlama teknikleri gibi etkinliklerle de psikososyal destek aldı. “Kadın olmak ortak bir kimlik. Katılımcılar hem avantajlarını hem de dezavantajlarını paylaştı” dedi.
Atölyeye oğlu ile katılan 2 çocuk annesi Halise Kaya (40), “Kendime vakit ayırmak psikolojime iyi geldi. Daha önce seramiğe ilgim yoktu ama güzel işler başardık” diye konuştu. 2 çocuk annesi Gönül Demir (47) ise, “Önce çekindim ama birlikte gülüp birlikte ağladık. Suriyeli kadınlarla ilk kez paylaşımda bulundum, çok keyif aldım” dedi.

Güvenli ve destekleyici alanlar
İzmir Büyükşehir Belediyesi Sosyal Hizmet Uzmanı Cansu Deniz Ağ, projeyle dezavantajlı gruplar için güvenli ve destekleyici alanlar oluşturduklarını belirtti: “Sanat temelli uygulamalar ve psikososyal destekle kadınların iyi oluşunu güçlendirmeyi hedefliyoruz. Bu proje, kapsayıcı sosyal hizmet modellerimizi yaygınlaştırmanın önemli bir parçası.”
İzmir Büyükşehir Belediyesi Sanat Eğitmeni Ebru İlbeyci Alkan da, “Sanat yalnızca üretim değil, buluşma ve birlikte güçlenme zemini. Katılımcılar güvenli bir ortamda kendilerini ifade ediyor ve ortak bir dil kurma fırsatı buluyor” ifadelerini kullandı.